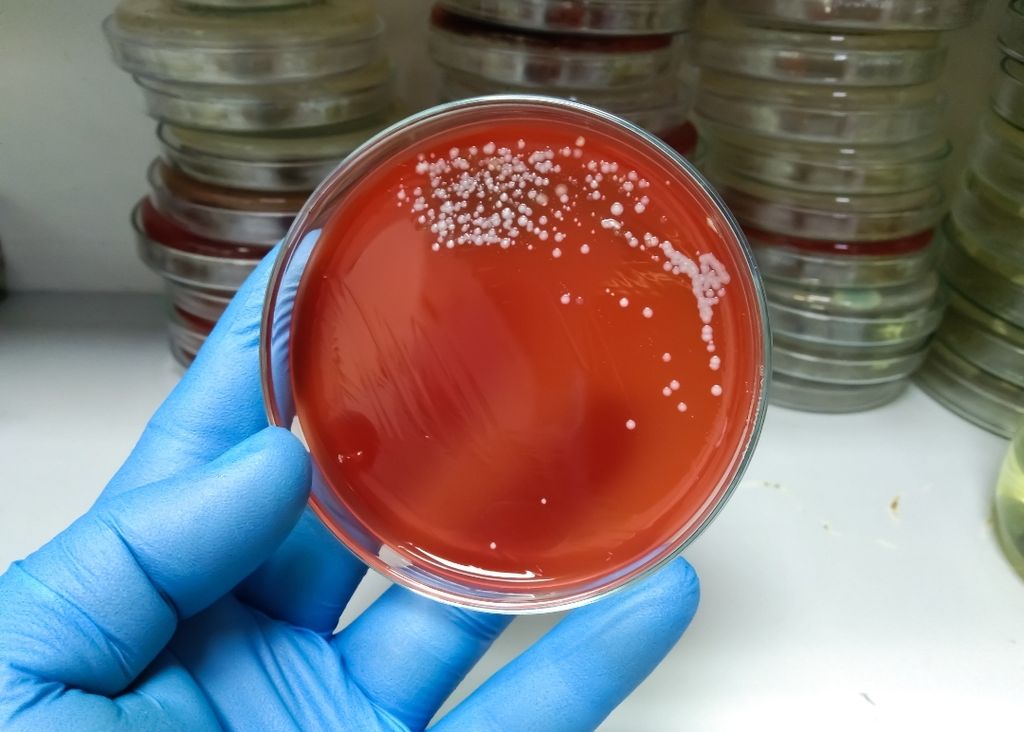
Screenshot_20240607_212125 Screenshot_20240607_212125

Temprana detección de la “bacteria asesina” es crucial para evitar complicaciones
7 de junio de 2024
El Ministerio de Salud confirmó la presencia de la “bacteria asesina” en el organismo de personas que fallecieron producto de influenza

· Profesor del Instituto de Biología de la Pontificia Universidad Católica de Valparaíso entregó detalles de lo peligrosa que puede llegar a ser la Streptococcus Pyogenes, la cual se detectó en el organismo de personas fallecidas debido a la influenza en Ñuble.
El Ministerio de Salud confirmó la presencia de la popularmente “bacteria asesina” en el organismo de personas que fallecieron producto de influenza en la región del Ñuble. Según el subsecretario de Redes Asistenciales, Osvaldo Salgado, se pudo detectar, tras los análisis a las personas que fallecieron producto de la influenza en El Ñuble, que hubo “varios casos” en donde se encontró la Streptococcus Pyogenes.
En ese sentido el profesor del Instituto de Biología de la Pontificia Universidad Católica de Valparaíso, Jorge Olivares, señalo que “la ‘bacteria asesina’ se encuentra normalmente en la microbiota faríngea de todas las personas y se asocia principalmente a enfermedades del tracto respiratorio superior, como la amigdalitis. Sin embargo, en la actualidad existen cepas muy virulentas que pueden ser adquiridas fundamentalmente a nivel intrahospitalario”.
Olivares agregó que “estas cepas ultra virulentas son muy peligrosas y pueden afectar gravemente, sobre todo, a quienes tienen deficiencia en sus sistemas inmunitarios, que podría ser el caso de las personas que padezcan influenza. Si bien, la influenza es una enfermedad viral, produce un gran deterioro en el sistema inmunitario de los pacientes”.
En cuanto a las medidas de prevención, Olivares señaló que “para evitar la diseminación de esta bacteria hay que llevar a cabo programas de vigilancia y seguimiento a aquellas personas con influenza, la cual al ser una enfermedad viral no debe ser tratada con antibióticos. Sin embargo, al detectarse la presencia de la ‘bacteria asesina’ se deben aplicar antibióticos para combatirla”.
Para el profesor del Instituto de Biología de la PUCV, “la detección temprana de la Streptococcus Pyogenes es fundamental. Se le llama ‘bacteria asesina’ debido a que causa la muerte en forma muy rápida, provocando septicemia a nivel generalizado en las personas haciendo que el tratamiento con antibióticos sea muy complejo”.

hace 6 días
Así quedó el vehículo cuyo chofer fue auxiliado por los equipos de emergencia que llegaron al lugar del accidente.

hace 2 días
El siniestrado inmueble forma parte del casco histórico del centro de la ciudad.

hace 3 días
El ex jefe comunal fue acusado de notable abandono de deberes.

hace 3 días
Más de seis meses duró la indagatoria policial antes de lograr la captura de esta banda chilena-colombiana.

hace 3 días
La comunidad ha esperado por más de una década la opción de acceder a este servicio básico.

hace 3 días
Un hombre fue detenido para quedar a disposición del Juzgado de Garantía de Castro.

hace 4 días
Infructuosas han sido las tareas hasta el momento por encontrar a Oscar Saldivia Remolcoy de isla Laitec.

hace 4 días
El fuego arrasó con todo el segundo piso del antiguo edificio de madera.

hace 4 días
La medida evitará que las viviendas sea vean amenazadas ante emergencias como la ocurrida en Villa San Valentín.

hace 4 días
La Dirección de Presupuesto tiene un plazo de 30 días para emitir un pronunciamiento.

hace 5 días
El proyecto "Paraíso Musical" tiene entusiasmados a los alumnos antes de su presentación en público.

hace 5 días
Una columna de humo se podía apreciar desde el sector alto de la ciudad en medio del fuerte viento.

hace 5 días
A diferencia de otras experiencias esta vez ha habido un aumento de cirugías en la población felina.

hace 5 días
Las tareas continúan aprovechando las favorables condiciones del tiempo en la zona.

hace 5 días
El Ministerio de Bienes Nacionales cedió en comodato un espacio que estaba en completo abandono.

hace 6 días
Así quedó el vehículo cuyo chofer fue auxiliado por los equipos de emergencia que llegaron al lugar del accidente.

hace 2 días
El siniestrado inmueble forma parte del casco histórico del centro de la ciudad.














